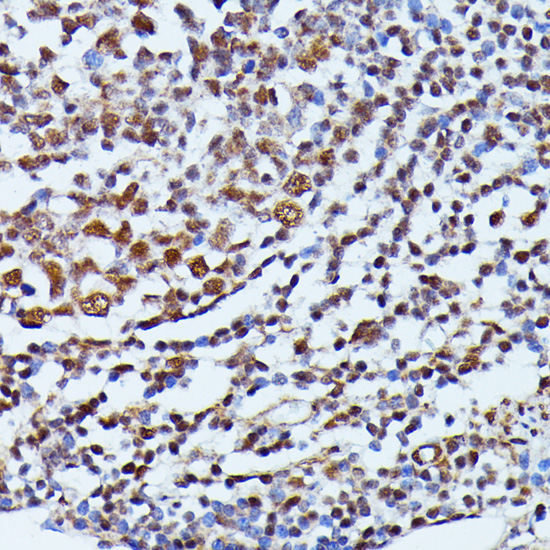
Immunohistochemistry - ID2 Polyclonal Antibody

-
Product Name
ID2 Polyclonal Antibody
- Documents
-
Description
Polyclonal antibody to ID2
-
Tested applications
WB, IHC
-
Species reactivity
Human, Mouse, Rat
-
Alternative names
ID2 antibody; GIG8 antibody; ID2A antibody; ID2H antibody; bHLHb26 antibody; DNA-binding protein inhibitor ID-2 antibody
-
Isotype
Rabbit IgG
-
Preparation
Antigen: Recombinant fusion protein containing a sequence corresponding to amino acids 75-134 of human ID2 (NP_002157.2).
-
Clonality
Polyclonal
-
Formulation
PBS with 0.02% sodium azide, 50% glycerol, pH7.3.
-
Storage instructions
Store at -20℃. Avoid freeze / thaw cycles.
-
Applications
WB 1:500 - 1:2000
IHC 1:50 - 1:200 -
Validations

Western blot - ID2 Polyclonal Antibody
Western blot analysis of extracts of mouse lung, using ID2 antibody at 1:1000 dilution.Secondary antibody: HRP Goat Anti-Rabbit IgG (H+L) at 1:10000 dilution.Lysates/proteins: 25ug per lane.Blocking buffer: 3% nonfat dry milk in TBST.Detection: ECL Enhanced Kit .Exposure time: 90s.

Immunohistochemistry - ID2 Polyclonal Antibody
Immunohistochemistry of paraffin-embedded rat ovary using ID2 antibody at dilution of 1:100 (40x lens).

Immunohistochemistry - ID2 Polyclonal Antibody
Immunohistochemistry of paraffin-embedded rat brain using ID2 antibody at dilution of 1:100 (40x lens).
Immunohistochemistry - ID2 Polyclonal Antibody
Immunohistochemistry of paraffin-embedded human appendix using ID2 antibody at dilution of 1:100 (40x lens).

Immunohistochemistry - ID2 Polyclonal Antibody
Immunohistochemistry of paraffin-embedded human oophoroma using ID2 antibody at dilution of 1:100 (40x lens).

Immunohistochemistry - ID2 Polyclonal Antibody
Immunohistochemistry of paraffin-embedded mouse liver using ID2 antibody at dilution of 1:100 (40x lens).
-
Background
Transcriptional regulator (lacking a basic DNA binding domain) which negatively regulates the basic helix-loop-helix (bHLH) transcription factors by forming heterodimers and inhibiting their DNA binding and transcriptional activity. Implicated in regulating a variety of cellular processes, including cellular growth, senescence, differentiation, apoptosis, angiogenesis, and neoplastic transformation. Inhibits skeletal muscle and cardiac myocyte differentiation. Regulates the circadian clock by repressing the transcriptional activator activity of the CLOCK-ARNTL/BMAL1 heterodimer. Restricts the CLOCK and ARNTL/BMAL1 localization to the cytoplasm. Plays a role in both the input and output pathways of the circadian clock: in the input component, is involved in modulating the magnitude of photic entrainment and in the output component, contributes to the regulation of a variety of liver clock-controlled genes involved in lipid metabolism.
Related Products / Services
Please note: All products are "FOR RESEARCH USE ONLY AND ARE NOT INTENDED FOR DIAGNOSTIC OR THERAPEUTIC USE"
